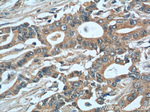
MIP-3 alpha Antibody in Immunohistochemistry (Paraffin) (IHC (P))

Search
Proteintech
MIP-3 alpha Polyclonal Antibody
{{$productOrderCtrl.translations['antibody.pdp.commerceCard.promotion.promotions']}}
{{$productOrderCtrl.translations['antibody.pdp.commerceCard.promotion.viewpromo']}}
{{$productOrderCtrl.translations['antibody.pdp.commerceCard.promotion.promocode']}}: {{promo.promoCode}} {{promo.promoTitle}} {{promo.promoDescription}}. {{$productOrderCtrl.translations['antibody.pdp.commerceCard.promotion.learnmore']}}
产品信息
26527-1-AP
种属反应
宿主/亚型
分类
类型
抗原
偶联物
形式
浓度
规格
纯化类型
保存液
内含物
保存条件
运输条件
产品详细信息
Immunogen sequence: ASNFDCCLG YTDRILHPKF IVGFTRQLAN EGCDINAIIF HTKKKLSVCA NPKQTWVKYI VRLLSKKVKN M (26-95 aa encoded by BC020698)
靶标信息
Macrophage Inflammatory Protein-3 alpha (MIP-3alpha), also called CCL20, is expressed in the liver, lungs, lymph nodes and peripheral blood lymphocytes. MIP-3alpha is strongly up regulated by inflammatory signals, and down regulated by the anti-inflammatory cytokine IL-10. MIP3alpha signals through the G protein-coupled receptor, CCR6, and acts as a chemoattractant to lymphocytes and dendritic cells.
仅用于科研。不用于诊断过程。未经明确授权不得转售。
生物信息学
蛋白别名: beta chemokine exodus-1; Beta-chemokine exodus-1; C-C motif chemokine 20; CC chemokine LARC; chemokine (C-C motif) ligand 20; Liver and activation-regulated chemokine; M-MIP-3-alpha; Macrophage inflammatory protein 3 alpha; MIP 3 a; MIP 3 α; MIP 3alpha; MIP 3α; MIP-3-alpha; MIP3 a; MIP3 alpha; MIP3 α; small inducible cytokine subfamily A (Cys-Cys), member 20; Small-inducible cytokine A20
基因别名: CCL20; CKb4; Exodus; LARC; MIP-3-alpha; MIP-3a; MIP3A; SCYA20; ST38
UniProt ID: (Human) P78556
Entrez Gene ID: (Human) 6364